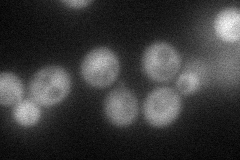
YLR019W
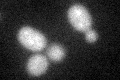
YLR019W

View description
Functionally redundant Psr1p homolog, a plasma membrane phosphatase involved in the general stress response; required with Psr1p and Whi2p for full activation of STRE-mediated gene expression, possibly through dephosphorylation of Msn2p
Localization:
Intensity:
Fold change:
Significance:
-
C’ GFP library in SD

below threshold14.01 -
N' NOP1pr-GFP in SD
cytosol61.217 -
N' TEF2pr-mCherry in SD

cytosol,nucleus81.8925 -
N' NATIVEpr-GFP in SD

cytosol,punctate32.8554 -
N' TEF2pr-VC and Cyto-VN in SD

cytosol34.2748 -
C’ GFP library in SD+DTT
cytosol13.960.99No -
C’ GFP library in SD+H2O2

cytosol14.821.05No -
C’ GFP library in Starvation Media

cytosol18.431.31No -
C’ GFP library on the background of Pup2-DaMP

below threshold -
C’ GFP library on the background of CCT mutant

below threshold13.29780.948275No
